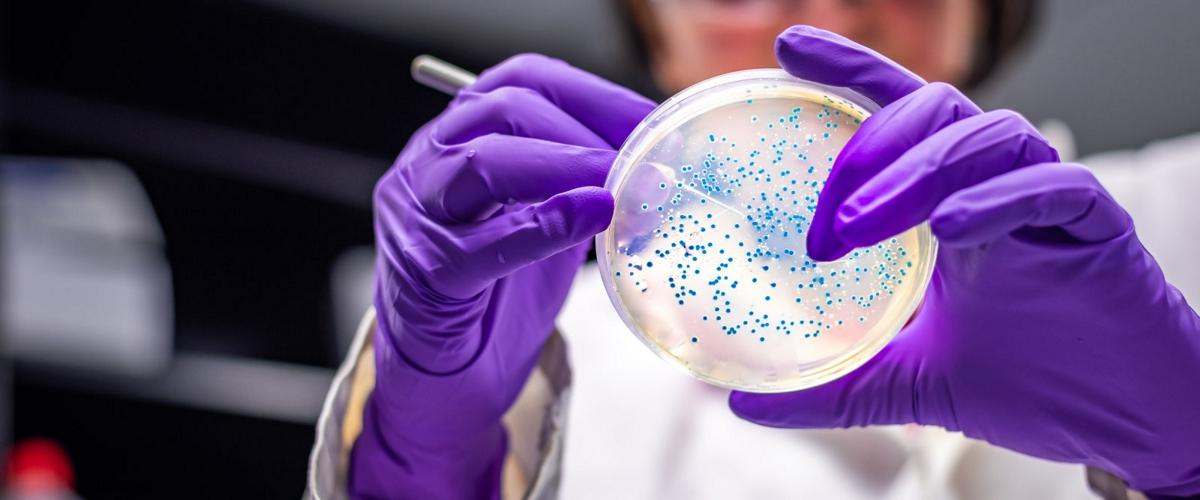
TODO:

Внутри нас обитают триллионы микробов, и все чаще ученые обращаются к кишечнику человека, чтобы понять, как бактерии влияют на состояние здоровья всего организма. Оказывается, мы выработали сложные симбиотические отношения с микробами, и когда равновесие в их популяции нарушается, это отражается на здоровье человека.
К примеру, предыдущие исследования уже установили, что травмы мозга приводят к изменениям в микробиоте кишечника, тогда как определенные бактерии могут стать причиной воспаления нервных тканей. Были и работы, посвященные связи микроорганизмов с нейродегенеративными заболеваниями, такими как болезнь Альцгеймера или Паркинсона. Новое исследование ученых из Научно-медицинского университета Орегона впервые показывает на примере мышей взаимоотношения между изменениями микробиоты и когнитивными способностями, сообщает New Atlas.
Ученые исследовали две группы мышей: одна группа состояла из носителей гена, ассоциированного с болезнью Альцгеймера, другая — контрольная. Обе находились в течение полугода в одинаковых условиях и питались одинаковой пищей.
Через шесть месяцев исследователи заметили существенные поведенческие и когнитивные различия между двумя группами. Отличия были также обнаружены в составе микробиоты. «Хотя все мыши питались одинаково, микробиота кишечника оказалась под действием генотипа, а это, в свою очередь, повлияло на мозг», — пояснил Джейкоб Рэбер, старший исследователь.
Дальнейшее изучение процессов позволило обнаружить корреляцию между отклонениями в микробиоте, зафиксированными у мышей с Альцгеймером, и эпигенетическими изменениями в тканях гиппокампа. По мнению Рэбера, причинно-следственные отношения не ясны, но очевидно, что есть связь между эпигенетическими изменениями мозга и определенными микробами кишечника.
«Микробы могут оказывать влияние на поведенческие и когнитивные параметры, релевантные для болезни Альцгеймера, через эпигенетические изменения в гиппокампе, — сказал он. — Или же может оказаться так, что эпигенетические изменения в гиппокампе воздействуют на микробиоту кишечника».
В прошлом году европейские ученые окончательно поставили точку в вопросе взаимосвязи микробиоты кишечника и развития нейродегенерации. Они подтвердили корреляцию между дисбалансом микробиоты кишечника и развитием амилоидных бляшек в головном мозге человека.